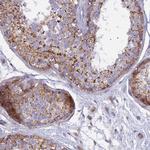
CLCN7 Antibody in Immunohistochemistry (Paraffin) (IHC (P))

Search
Invitrogen
CLCN7 Polyclonal Antibody
{{$productOrderCtrl.translations['antibody.pdp.commerceCard.promotion.promotions']}}
{{$productOrderCtrl.translations['antibody.pdp.commerceCard.promotion.viewpromo']}}
{{$productOrderCtrl.translations['antibody.pdp.commerceCard.promotion.promocode']}}: {{promo.promoCode}} {{promo.promoTitle}} {{promo.promoDescription}}. {{$productOrderCtrl.translations['antibody.pdp.commerceCard.promotion.learnmore']}}
产品信息
PA5-60203
宿主/亚型
分类
类型
抗原
偶联物
形式
浓度
规格
保存条件
运输条件
RRID
产品详细信息
Immunogen sequence: LYDMHIQLQS VPFLHWEAPV TSHSLTAREV MSTPVTCLRR REKVGVIVDV LSDTASNHNG FPVVEHADDT QPARLQGLIL RSQLIVLLKH KVFVERS
Highest antigen sequence identity to the following orthologs: Mouse - 96%, Rat - 96%.
靶标信息
The product of this gene belongs to the CLC chloride channel family of proteins. Chloride channels play important roles in the plasma membrane and in intracellular organelles. This gene encodes chloride channel 7. Defects in this gene are the cause of osteopetrosis autosomal recessive type 4 (OPTB4), also called infantile malignant osteopetrosis type 2 as well as the cause of autosomal dominant osteopetrosis type 2 (OPTA2), also called autosomal dominant Albers-Schonberg disease or marble disease autosoml dominant. Osteopetrosis is a rare genetic disease characterized by abnormally dense bone, due to defective resorption of immature bone. OPTA2 is the most common form of osteopetrosis, occurring in adolescence or adulthood.
仅用于科研。不用于诊断过程。未经明确授权不得转售。